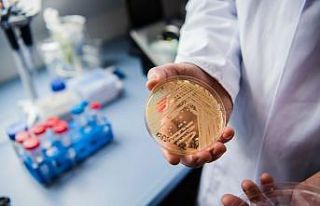
Ölümcül mantarla, yapay zeka desteği ile mücadele...

Yozgat’ın Çekerek ilçesinde tekme tokat birbirine giren kızların kavgası, bir iş yerinin güvenlik kamerasına yansıdı.
Edinilen bilgiye göre kavga Atatürk Bulvarı’nda meydana geldi. İki grup halinde bir araya gelen genç kızlar arasında bilinmeyen nedenle tartışma başladı. Tartışma kısa sürede kavgaya dönüşürken, kızlar birbirlerine tekme tokat saldırdı. Çevredeki esnafın araya girmesiyle kızlar güçlükle ayrıldı.
Yaşanan kavga bir iş yerinin güvenlik kamerasına yansıdı.